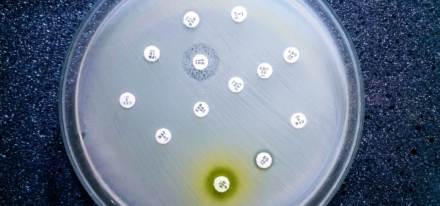
L’OMS alerte sur une résistance mondiale croissante aux antibiotiques

- Rémunération des pharmaciens : une réforme majeure se prépare-t-elle ?
- Vaccination antigrippale en pharmacie : vacciner dès maintenant, oui ou non ?
- Les métiers de l’officine enfin reconnus à risques ergonomiques
- Salaires et nouvelle grille des coefficients : le compte à rebours a commencé
- Remises génériques : l’arrêté rectificatif en passe d’être publié
- Comptoir officinal : optimiser l’espace sans sacrifier la relation patient
- Reishi, shiitaké, maitaké : la poussée des champignons médicinaux
- Budget de la sécu 2026 : quelles mesures concernent les pharmaciens ?
- Cancers féminins : des voies de traitements prometteuses
- Vitamine A Blache 15 000 UI/g : un remplaçant pour Vitamine A Dulcis
Publicité
Publicité

Publicité

à partir de 22,50 € par mois !
Abonnez-vous
au Moniteur des pharmacies
et ne manquez aucun numéro
Abonnez-vous
Formation Tout sur Formation

Prise de tension sur un vêtement : on lui répond quoi ?
Formations en ligne & présentielles

Nouveau service pour la formation continue des équipes officinales
Nouveau 

Dénutrition des séniors : le pharmacien en première ligne
Voir le programme
DPC FIF PL OPCO EP
Nouveau 

Anxiété et dépression : Votre rôle de pharmacien face à ces défis
Voir le programme
DPC FIF PL OPCO EP
Nouveau 

Tabac : Engagez-vous en prévention santé : De la première puff au dernier paquet
Voir le programme
DPC FIF PL OPCO EP
Business Tout sur Business
DATA

Marché des produits de la ruche
Top 5 des produits

Voir les tendances du marché

Actuellement dans les annonces
Emploi
Transaction

Déposer une annonce
Vous souhaitez publier une annonce dans la revue ou sur internet et profiter de la réactivité de notre communauté ?
Publier mon annonce
Médicaments Tout sur Médicaments

MédicInfo
Fiches et répertoire de médicaments
Présentations, statut, alertes ANSM, SMR, ASMR... Retrouvez toute l'information réglementaire et administrative des médicaments.
Base actualisée tous les mois !
ACCÉDER À LA BASE MÉDICINFO
Base actualisée tous les mois !
Les plus consultés

Près de 500 médicaments à délivrance particulière
pour répondre clairement aux besoins exprimés par la profession et délivrer en toute sécurité.
pour répondre clairement aux besoins exprimés par la profession et délivrer en toute sécurité.
S’ABONNER
à partir de
8,25€ par mois !
8,25€ par mois !

LE MONITEUR PODCASTS
Anxiolytiques et hypnotiques : rester zen
Alexandra Blanc, docteure en pharmacie, chargée de la rubrique formation du Moniteur des pharmacies, vous propose de la suivre dans une série de podcasts destinés à approfondir et à actualiser vos connaissances sur les règles de dispensation des médicaments.
La librairie du Moniteur des pharmacies
Retrouvez tous les ouvrages pour les métiers de l’officine à destination des pharmaciens, étudiants en pharmacie, préparateurs et élèves préparateurs.
5% de remise sur les livres pour nos abonnés à nos revues et services, hors packs et hors prix déjà remisés.
Voir tous les livresLégislation Tout sur Législation
La Question
de droit
de droit
Adjointe, je travaille 3 dimanches par mois et presque tous les jours fériés. Dois-je être payée en heures supplémentaires ?
La réponse : Hors période de garde, le salarié perçoit son salaire habituel. En conséquence, votre rémunération du dimanche... > Lire la suite

Temps de travail et congés
Cumul d’emploi en officine : 5 règles à connaître

Salaires
Salaires et nouvelle grille des coefficients : le compte à rebours a commencé


Un service de renseignements juridiques personnalisé et adapté à l'exercice officinale pour vous aider à prendre les bonnes décisions.
S’ABONNER
à partir de
1 € le premier mois !
1 € le premier mois !
Profession Tout sur Profession



Thérapeutique Tout sur Thérapeutique

Nouvelles missions Tout sur Nouvelles missions


Conseils Tout sur Conseils



Préparateurs Tout sur Préparateurs


























